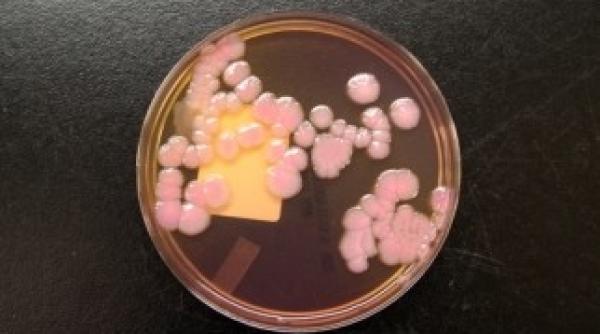
vezi care este bacteria rezistenta la toate medicamentele

Publicat pe 16 Mar 2013

Ioan Isaiu din Secretul Mariei a murit după o postare politică. Cum au explodat conspirațiile despre PSD, AUR și vaccin
Ioan Isaiu din Secretul Mariei a murit după o postare politică. Cum au explodat conspirațiile despre PSD, AUR și vaccin
de Anca Murgoci